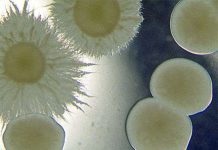
Kiểu “yêu” dị thường của mầm bệnh gây chết người Kiểu "yêu" dị thường của mầm bệnh gây chết người

Trong hoang mạc Tây Bắc Trung Quốc có một loại cây cao to gọi là Hồ dương hoặc Hồ đồng. Khác với những cây dương thông thường, loài hồ dương có sức chống chịu mạnh mẽ đối với khô hạn, khí hậu thay đổi ác liệt và đất mặn. Trong sa mạc Tacramakan ở Tân Cương, nước ngầm có hàm lượng muối rất cao, nó vẫn sống xanh tươi rậm rạp.
|
(Ảnh: rmhb.com) |
Bộ rễ hồ dương ăn sâu tới trên 10m, trong cây dự trữ rất nhiều nước đề phòng khô hạn. Tế bào của nó có chức năng đặc biệt là không bị muối làm tổn thương. Nồng độ dịch tế bào rất cao, có thể hút liên tục nước ngầm mặn và dinh dưỡng. Bẻ cành hồ dương, chỗ đứt khô đi để lại kiềm sinh vật, chất này có thể ăn, làm xà phòng hoặc thuốc da. Một cây hồ dương mỗi năm sản xuất được mấy chục cân kiềm sinh vật.
Hồ dương là một trong những cây cổ xưa, hơn 60 triệu năm trước đã có mặt trên trái đất. Đó là cây thân gỗ, rụng lá, cao 15-30m, cây non và cành non mọc lông mềm dày đặc, lá rất to có lông gai khi cây còn non, hình tuyến (dài). Khi cây già, lá bầu dục hoặc hình trứng nên người ta còn gọi là dương khác lá. Hoa tím đỏ dạng kim, quả sóc bầu dục dài. Hồ dương có thể mọc cây non từ rễ để mở rộng địa bàn của mình.
Hồ dương mọc nhanh, dá dùng làm thức ăn cho gia súc, gỗ chống ẩm, không mục, là vật liệu làm cầu rất tốt; cũng có thể làm giấy hoặc đóng đồ dùng gia đình. Hồ dương trồng để chắn cát, tạo cây xanh, bảo vệ đồng ruộng.
(Ảnh: chemsrv0)
Theo H.T (Thế giới thực vật)